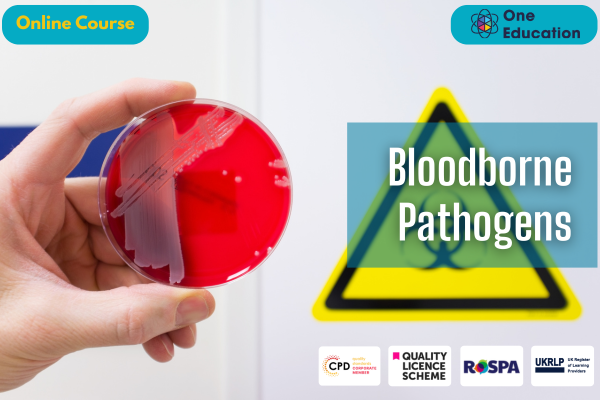

Bloodborne Pathogens
Course
Online

Description
-
Type
Course
-
Level
Intermediate
-
Methodology
Online
-
Class hours
3h
-
Duration
1 Year
-
Online campus
Yes
The Bloodborne Pathogens online course provides essential knowledge for anyone who may come into contact with infectious biological materials in their workplace or daily life. Learners will explore the nature, transmission, and prevention of bloodborne pathogens, including HIV, Hepatitis B, and Hepatitis C. This course covers risk assessment, infection control measures, and safe practices for handling potentially infectious materials.
Designed for professionals across healthcare, laboratory, first response, and cleaning sectors, this course ensures participants understand how to protect themselves and others from exposure. Through clear, structured modules, learners develop practical skills for implementing safety protocols, recognising hazards, and responding effectively to exposure incidents.
Studying this course enhances workplace safety knowledge, supports compliance with UK and international health regulations, and strengthens career prospects in roles where infection control is critical. With its flexible online format, learners can study at their own pace, making it ideal for busy professionals seeking recognised training in bloodborne pathogen safety.
Important information
Price for Emagister users:
About this course
Understand bloodborne pathogens and their modes of transmission
Identify workplace hazards and risks associated with infectious materials
Implement effective infection control and safety procedures
Respond appropriately to exposure incidents
Comply with UK and international health and safety regulations
Enhance workplace safety and personal protection skills
Apply knowledge to improve professional practice and career development
This course is suitable for a wide range of learners, including healthcare workers, laboratory technicians, first responders, cleaning and maintenance staff, and anyone whose role may involve exposure to blood or bodily fluids. It is ideal for individuals seeking to improve workplace safety knowledge, meet regulatory compliance standards, or enhance their professional credentials.
Whether you are starting your career or seeking to update your skills, the Bloodborne Pathogens course offers practical knowledge applicable across multiple industries. Learners from diverse backgrounds, including clinical, educational, and support services, will benefit from understanding infection control principles. The course is designed to be accessible, inclusive, and immediately applicable in professional settings.
No formal entry requirements are needed for this course. It is suitable for learners aged 16 and above. Participants should have a good command of English, basic numeracy skills, and familiarity with IT, such as using a computer and navigating online platforms. This ensures that learners can fully engage with course materials, complete assessments, and access learning resources effectively.
Upon successful completion of the Bloodborne Pathogens course, you will qualify for a UK and internationally recognised professional certification. You may also choose to formalise your achievement by obtaining your PDF Certificate for £9 or a Hardcopy Certificate for £15.
The Bloodborne Pathogens course offers complete flexibility, allowing learners to study at their own pace and on their own schedule. Expert-designed modules provide clear, concise content focused on practical applications and career relevance. This course equips learners with skills that improve workplace safety, demonstrate professional commitment, and enhance a CV. The self-paced online format ensures accessibility for busy professionals while maintaining high-quality, career-focused learning outcomes.
This course is designed to be accessible to learners of all levels, including those new to infection control concepts. Modules are structured in clear, concise sections with practical examples to aid understanding. Self-paced learning allows participants to revisit content as needed, ensuring comprehension before progressing. The course balances foundational knowledge with essential workplace applications, making it suitable for beginners and those seeking to refresh their skills.
Completing the Bloodborne Pathogens course demonstrates a commitment to workplace safety and professional development. Learners gain practical knowledge applicable in healthcare, laboratory, emergency response, cleaning, and support roles. The certification enhances employability, strengthens CVs, and supports compliance with UK and international safety regulations, providing a recognised qualification for a wide range of professional pathways.
The course is entirely online, allowing learners to access content from any location at a time that suits them. Structured modules guide participants through key topics, with assessments to track progress and reinforce learning. The digital format provides convenience, flexibility, and ongoing access to resources, making it easy for busy professionals or students to fit learning into their schedules while maintaining high-quality outcomes.
Reviews
This centre's achievements
All courses are up to date
The average rating is higher than 3.7
More than 50 reviews in the last 12 months
This centre has featured on Emagister for 8 years
Subjects
- Bloodborne
- Pathogens
- Risks
- Prevention
- Handling
Teachers and trainers (1)
One Education
Course Provider
Course programme
A Bloodborne Pathogens course educates learners on the risks, prevention, and safe handling of infectious materials that can transmit diseases such as HIV, hepatitis B, and hepatitis C. The training covers modes of transmission, exposure control plans, proper use of personal protective equipment (PPE), and emergency procedures in case of exposure. Learners gain the knowledge and practical skills to protect themselves and others in workplaces where contact with blood or bodily fluids may occur, ensuring safety and regulatory compliance.
Course Curriculum
- Module 01 Introduction to Bloodborne Pathogens
- Module 02 Regulatory Standards and Guidelines
- Module 03 Prevention and Control Measures
- Module 04 Exposure Incident Response
- Module 05 Risk Assessment and Management
- Module 06 Vaccination Programs
- Module 07 Workplace Policies and Procedures
Bloodborne Pathogens